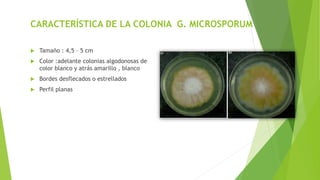
CARACTERÍSTICA DE LA COLONIA G. MICROSPORUM
 Tamaño : 4,5 – 5 cm
 Color :adelante colonias algodonosas de
color blanco y atrás amarillo , blanco
 Bordes desflecados o estrellados
 Perfil planas

Este documento describe las características taxonómicas, morfológicas y de cultivo de tres géneros de hongos dermatofitos: Microsporum, Epidermophyton y Trichophyton. Incluye información sobre sus especies, hábitat natural, factores de virulencia, características celulares y coloniales, y las enfermedades que causan en humanos y animales.